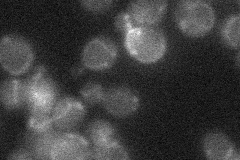
YDR185C
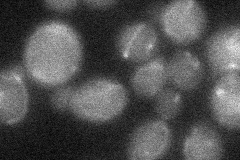
YDR185C
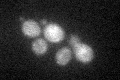
YDR185C
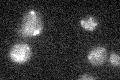
YDR185C

View description
Mitochondrial protein of unknown function; similar to Ups1p and Ups2p which are involved in regulation of mitochondrial cardiolipin and phosphatidylethanolamine levels; null is viable but interacts synthetically with ups1 and ups2 mutations
Localization:
Intensity:
Fold change:
Significance:
-
C’ GFP library in SD

mitochondria21.51 -
N' NOP1pr-GFP in SD

mitochondria56.2027 -
N' TEF2pr-mCherry in SD

mitochondria9.6038 -
N' NATIVEpr-GFP in SD
below threshold23.1099 -
N' TEF2pr-VC and Cyto-VN in SD
mitochondria24.4599 -
C’ GFP library in SD+DTT
mitochondria16.960.78Yes -
C’ GFP library in SD+H2O2

mitochondria20.260.94No -
C’ GFP library in Starvation Media
mitochondria17.080.79Yes -
C’ GFP library on the background of Pup2-DaMP

mitochondria -
C’ GFP library on the background of CCT mutant

mitochondria17.80520.827373No
